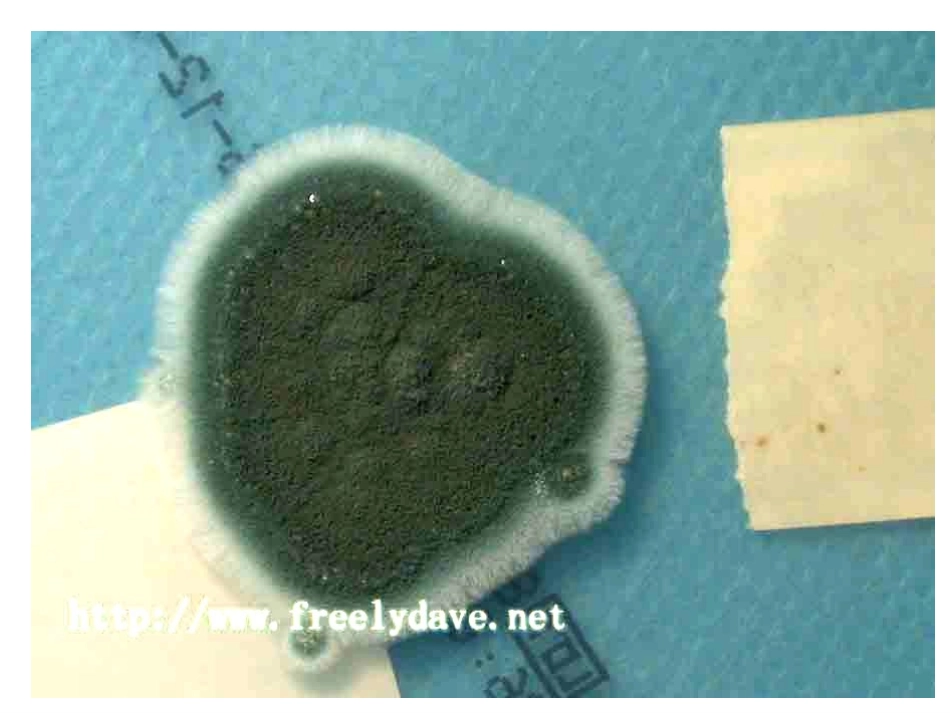
《面包发霉了》课件_第1页

观察发霉的面包●直接观察原来面包上长了许多霉菌
面包发霉是因为在它上面生长了一种——霉菌,与其他生物一样,霉菌的生长需要获取营养和适宜的生长环境
温馨提示:因为食物在霉变过程中产生的霉菌含有对人体有害的物质,所以发霉变质的食物是绝对不能食用的
用放大镜和显微镜观察放大镜下的霉菌孢子囊菌丝显微镜下的霉菌苹果、桔子、香蕉、米饭、蛋糕
等等还有哪些食物在存放过程中会发霉菌
面包上为什么会长霉菌
面包发霉与哪些因素有关
(1)可能与水分多少有关;(2)可能与温度高低有关;(3)可能与光照有关;
准备两块烘干的面包,(用牙签在每块面包上放一些霉菌),让第一块面包保持干燥,在第二块面包上滴10滴水,分别装在两个塑料袋内,用线扎紧袋口放在桌上
改变的条件:干燥常温和潮湿常温第一组:实验干燥常温环境潮湿常温环境准备两块烘干的面包,(用牙签在每块面包上放一些霉菌),都滴10滴水,分别装在两个塑料袋内,用线扎紧袋口放在桌上让第一块面包放进冷藏室,将第二块面包放在温暖的室温中
改变的条件:潮湿低温和潮湿高温第二组:实验潮湿低温环境内潮湿高温环境内第一组第二组第一块面包(干燥常温)第二块面包(潮湿常温)第三块面包(潮湿低温)第四块面包(潮湿高温)第一天第二天第三天第四天第五天第六天第七天面包发霉实验记录表面包等食物放久了有的要长霉菌,霉菌生长需要湿润、温暖的环境,也需要获取营养
判断题:1、食物在保存的过程中也会发生变化
()2、食物在霉变过程中产生的霉菌含有对人体有害的物质
()3、已经发霉的食物,扔掉可惜,洗一洗就可以吃了
()4、我们把第一块面包放在干燥、常温的地方,把第二块面包放在潮湿常温的地方,是为了研究水分对霉菌生长速度的影响
()判断题:1、食物在保存的过程中也会发生变化
()2、食物在霉变过程中产生的霉菌含有对人体有害的物质
()3、已经发霉的食